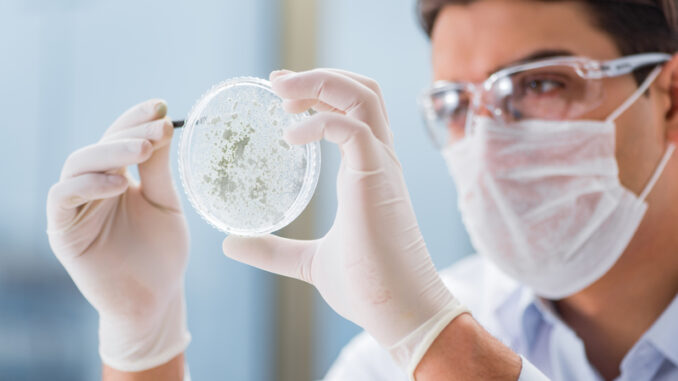

They’re using this 1 discovery to beat the odds
Unsubscribe | Report as spam | Change email preferences
Hey, Matt Cook here, and you might have seen this in the news recently:
Every major news outlet is reporting on it.
ABC News, CNN, Fox, NBC Nightly…
And every single one of these networks are running with the same story…
That more and more people are surviving cancer…
…even though cancer rates continue going up…
And the reason why more people are surviving cancer?
The news outlets keep saying it has to do with the amount of cancer research Big Pharma’s been doing…
And how they’ve come out with 10-12 new cancer treatments in the last few years…
The news outlets are giving Big Pharma all the credit.
They want you to think that chemo and experimental treatments are actually curing cancer…
But they’re not.
What’s really helping men defeat and survive cancer is actually completely natural…
…cheap…
…and probably already in your house right now.
Warmly,
–Matt Cook